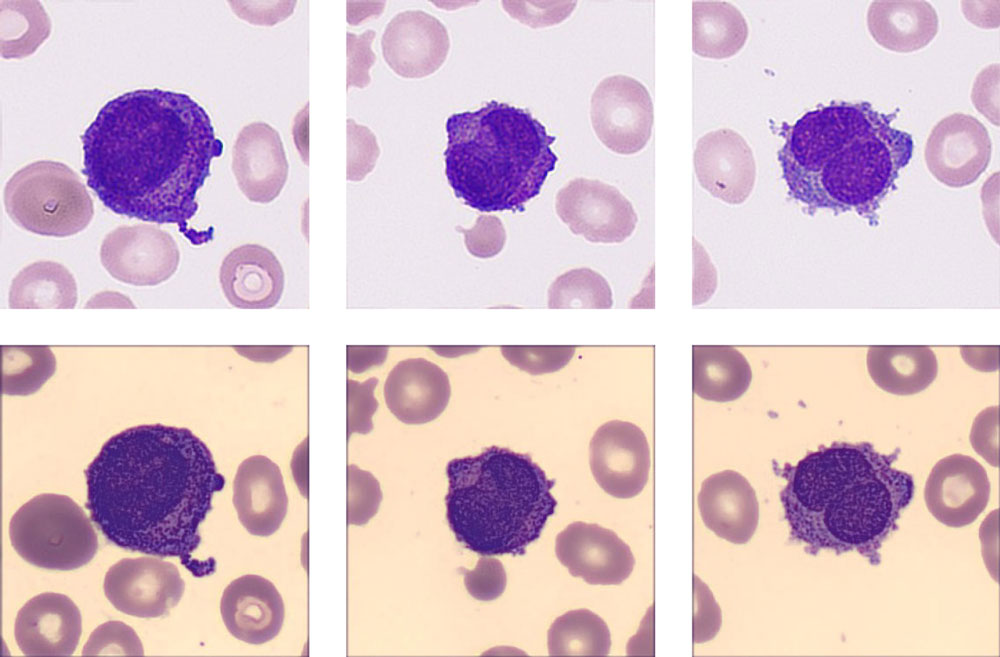
gln57-s6

HemaBook Chapter 12: A Clearer Truth? Find it Faster!
Mindray 2021-08-01

In the laboratory, what is the most common reason for you to gather with colleagues to look at and discuss samples or patient results on the screen or in a report?
?
The answers may vary. One of the reasons may be to discuss the special cell cases you find in a morphological examination. The routine hematology analysis is one of the most important screening tools among in-vitro diagnostics methods. The professionalism of the pathologist guarantees fast and accurate diagnosis based on the results from hematology analysis. Experienced and skilled cell morphology experts, in particular, play a vital role in it.
A Clinical Case
A 63-year-old male patient came to the hospital for treatment. He was quickly admitted to the Rheumatology Department because of his advanced age, pale complexion, sore throat, and a long history of hypertension and hyperuricemia.

The hematology results showed pancytopenia and flagged many causes for concern, including anemia, thrombocytopenia, white blood cell abnormal scattergram, and immature granulocytes.
?
The re-exam rule was triggered, so the doctor carried out the smear and stained it in the slide marker. The current digital cell morphology system read the blood smear automatically, and a high percentage of blasts and a few immature granulocytes were found.


ŌĆ£My god! Look at this!ŌĆØ One technician exclaimed. He read the same slide on the hospitalŌĆÖs trial digital cell morphology system from Mindray, where he found a more critical signal. In addition to high numbers of blast cells, a new cell type ŌĆ£Abnormal promyelocyteŌĆØ appeared on the screen, with a percentage as high as 33.5%!
Many typical characteristics had been found in these cells, such as the abondent purple-red auer rods, the orange-red cytoplasm particles like sunset clouds, and two leaf-like nuclei. The laboratory immediately decided to report the cirital values to the clinical department.
The patient was quickly treated with all-trans retinoic acid (ATRA) + arsenic program, and then fluorescence in situ hybridization (FISH) confirmed a chromosome translocation of t(15;17) (q22;q12) forming the fusion gene PML/RAR╬▒.

About PML/RAR╬▒
In the 1970s, a group of French, American, and British leukemia experts divided AML into subtypes, M0 through M7, based on the type of cell where the leukemia develops and how mature those cells are. Acute promyelocytic leukemia (APL) is the subtype AML-M3 using the French-American-British (FAB) classification. By taking into account many of the factors that are now known to affect prognosis, the World Health Organization (WHO) system updated the classification of AML in 2016. APL with the PML- RAR╬▒ fusion gene was independently listed, as PML/RAR╬▒ is the central leukemia-inducing lesion in APL. It is directly targeted by all trans retinoic acid (ATRA) and by arsenic, with both compounds able to induce complete remissions (CRs).

Clinically, it is critical that APL is distinguished from other AML subtypes quickly, because of:
?
- Its life-threatening bleeding disorders in case of delay in the proper treatment
- Its achievement of CRs in about 90% of APL patients upon ATRA treatment
- Its induction of CRs in 75ŌĆō90% of APL patients upon exposure to low-dose arsenic trioxide
?
However, the low incidence of PML/RAR╬▒ and the rapid deterioration of the disease mean that rapid diagnosis and the timely and successful treatment of patients are still huge challenges facing medical professionals today.
Conclusion
Although there are a variety of digital cell morphology systems with automatic cell classification on the market, there are still problems with insufficient recognition ability and low levels of efficiency. It takes a lot of manpower to check and confirm abnormalities on the cell image, and even check the smear under the microscope again.
?
Mindray provides reliable hematology solutions that can deliver efficient, accurate information about the true conditions of patients, helping health professionals, especially morphology experts, to find abnormalities, identify emergencies, as well as treat and cure patients fast.
References:
[1] J. Bennet, D. Catovsky, M.-T. Daniel, et al. Proposals for the classification of the acute leukaemias. Br J Haematol, 33 (1976), pp. 451-458
[2] C.M. Segeren, M.B. uan ŌĆśt Veer, The FAB classification for acute myeloid leukaemia-is it outdated? Netherlands Journal of Medicine 49 (1996) 126-131
[3] Puccetti, E., Ruthardt, M. Acute promyelocytic leukemia: PML/RAR╬▒ and the leukemic stem cell. Leukemia 18, 1169ŌĆō1175 (2004). https://doi.org/10.1038/sj.leu.2403367
[4] ARBER et al, The 2016 revision to the World Health Organization classification of myeloid neoplasms and acute leukemia, Blood (2016) 127 (20): 2391ŌĆō2405. https://doi.org/10.1182/blood-2016-03-643544
